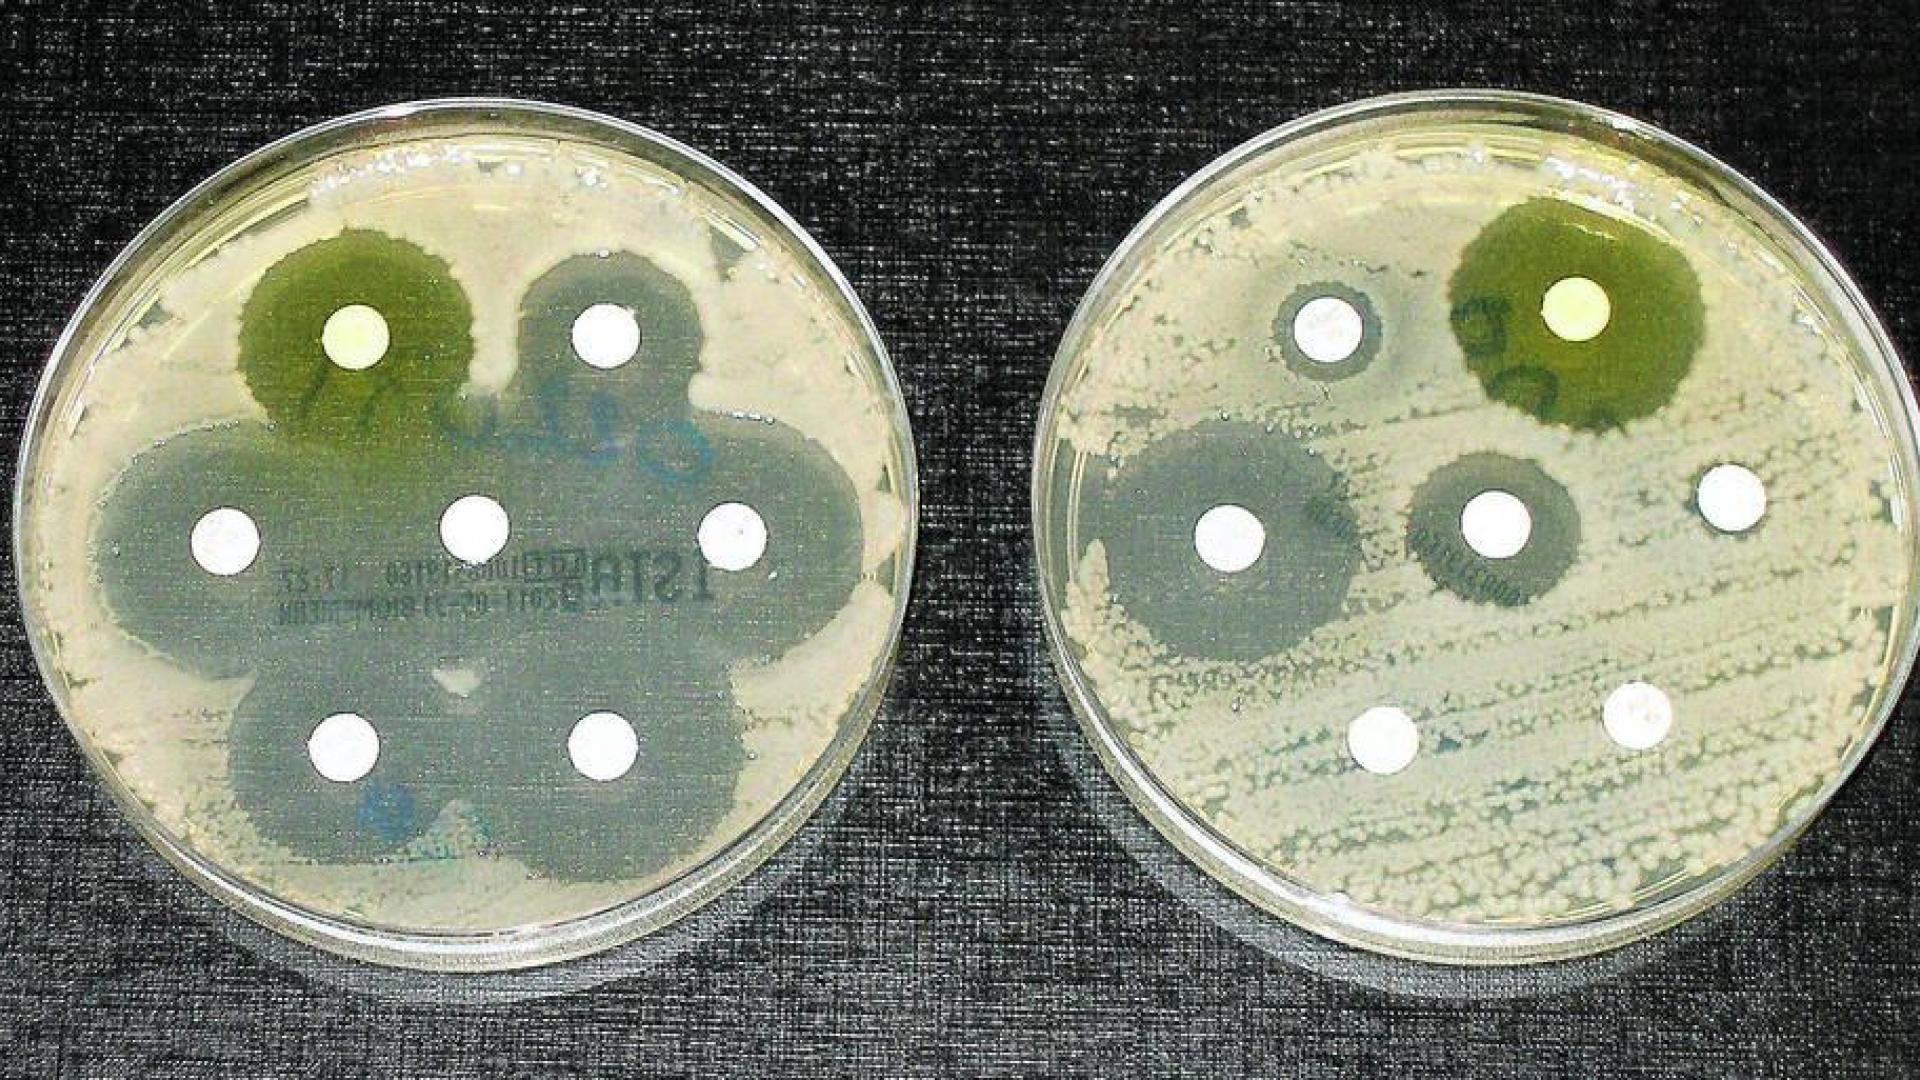
Bacterias resistentes a los antibióticos: un problema serio

Ciencia
Superbacterias: un peligro real, presente y futuro
En la actualidad, las bacterias resistentes a los antibióticos son responsables de 700.000 muertes al año

Publicado el 18/11/2020 a las 09:23
“Llegará un día en que cualquier persona pueda comprar la penicilina en las tiendas. Entonces existirá el peligro de que un hombre ignorante pueda fácilmente tomar una dosis insuficiente, y que al exponer a sus microbios a cantidades no letales del fármaco los haga resistentes”.
Estas palabras proféticas fueron pronunciadas por Alexander Fleming el 11 de diciembre de 1945, en el discurso que ofreció durante la ceremonia de concesión del premio Nobel.
En la actualidad, las bacterias resistentes a los antibióticos son responsables de 700.000 muertes al año. La situación no va a mejorar y se estima que en el año 2025 muchos de los antibióticos habituales serán ineficaces frente a las llamadas “superbacterias”. La globalización favorece que los nuevos tipos de resistencia a los antimicrobianos traspasen las fronteras y se extiendan sin apenas esfuerzo por los continentes. Estas se propagan a una velocidad vertiginosa y el creciente aumento de la resistencia a los antibióticos ya está desbocado, amenazando con originar una crisis sanitaria crítica a nivel mundial.
Es fundamental advertir a la sociedad sobre el fenómeno mundial de la resistencia a los antibióticos. Por ello, en una reunión celebrada en mayo de 2020, la Organización de las Naciones Unidas para la Agricultura y la Alimentación (FAO), la Organización Mundial de Sanidad Animal (OIE) y la Organización Mundial de la Salud (OMS) decidieron que, a partir de 2020, la Semana mundial de concienciación sobre el uso de los antimicrobianos se celebrará todos los años del 18 al 24 de noviembre. El lema será "Antimicrobianos: manéjalos con cuidado".
El problema principal es que nos estamos quedando sin alternativas con las que tratar patógenos específicos, en particular aquellos que causan infecciones adquiridas en el hospital, pero que tienen potencial de extenderse por toda la comunidad. Esto indica que la resistencia a los antibióticos podría convertirse en una catástrofe global que, de momento, no muestra signos de disminuir.
Las predicciones apuntan que para el año 2050 las superbacterias pueden causar 10 millones de muertes anuales en todo el mundo. Además, los problemas de salud derivados de las resistencias a los antibióticos podrían costarle al planeta un billón de euros anuales en atención médica, lo que conduciría a una reducción de entre el 2 % y el 3,5 % en el producto interior bruto.
La OMS ha listado a las bacterias patógenas multirresistentes en tres grupos de prioridad:
- El grupo 1: prioridad crítica. Incluye a Acinetobacter baumannii, Pseudomonas aeruginosa y algunas enterobacterias como Klebsiella pneumonie, Escherichia coli y varias especies de los géneros Serratia y Proteus. Todas ellas son resistentes a los carbapenémicos.
- El grupo 2: prioridad elevada. Incluye a Enterococcus faecium (resistente a la vancomicina), Staphylococcus aureus (resistente a la meticilina y con sensibilidad intermedia y resistencia a la vancomicina), Helicobacter pylori (resistente a la claritromicina), Campylobacter spp. (resistente a las fluoroquinolonas), Salmonella (resistente a las fluoroquinolonas) y Neisseria gonorrhoeae (resistente a la cefalosporina y a las fluoroquinolonas).
- El grupo 3: prioridad media. Incluye a Streptococcus pneumoniae (sin sensibilidad a la penicilina), Haemophilus influenzae (resistente a la ampicilina) y Shigella spp. (resistente a las fluoroquinolonas).

Resistencias que llevan décadas fraguándose
En la década de 1980, se descubrió que algunas cepas de Klebsiella pneumonie eran resistentes a muchos antibióticos betalactámicos, grupo al que pertenece la penicilina y que son de los más recetados. Las cepas de Klebsiella pneumonie eran capaces de producir unas enzimas llamadas betalactamasas que inactivaban químicamente a los antibióticos betalactámicos. Este fenómeno anunció la primera ola de resistencia a los antibióticos observada en esta bacteria.Era una muy mala noticia y, lejos de mejorar, el tema fue a peor.
Para poder tratar las infecciones resistentes a los betalactámicos, empezó a emplearse un grupo de antibióticos llamados carbapenémicos, que son un tipo de betalactámicos de última generación y que durante un tiempo fueron muy eficaces.
Por desgracia, en 1996 se observó que las bacterias habían desarrollado otra enzima llamada carbapenemasa que tenía la capacidad de hidrolizar y destruir los antibióticos carbapenémicos.
En el año 2009, la bacteria Klebsiella pneumonie mostró un nuevo mecanismo de resistencia a los antibióticos, era una metalo-betalactamasa que producían las bacterias resistentes encontradas en un paciente diabético al que se había administrado múltiples antibióticos tras ser sometido a cirugía en un hospital en Nueva Delhi. En el mismo paciente también se encontró una cepa de Escherichia coli que poseía el mismo tipo de mecanismo de resistencia y que le había sido transmitido por Klebsiella pneumonie.
Este intercambio de resistencias entre diferentes especies afea mucho el panorama futuro.
Las multirresistencias obligaron a administrar un potente antibiótico que es considerado un último recurso: la colistina (polimixina E). Este fármaco altera la membrana celular de la bacteria y causa así su muerte, pero hay que emplearlo con precaución porque produce cierta toxicidad en el sistema nervioso y en los riñones humanos.
En el año 2010 se descubrió que algunas cepas de Klebsiella pneumonie también eran resistentes a la colistina. En el año 2015, el descubrimiento de resistencia a la colistina mediada por plásmidos que transportaban el gen mcr-1, tanto en Escherichia coli como en Klebsiella pneumoniae aisladas de humanos y de animales, provocó una aguda preocupación mundial sobre la posibilidad de transferencia horizontal de este gen entre los aislados humanos y animales.
Históricamente, la colistina se utilizó por primera vez en la década de 1950 de forma intravenosa. La colistina y la polimixina B se han utilizado durante décadas en medicina veterinaria con fines profilácticos y terapéuticos. Desafortunadamente la resistencia cruzada entre la colistina y la polimixina B es casi del 100 %.
En el año 2017, los funcionarios de salud pública de Nevada informaron sobre el caso de una mujer que murió en Reno en septiembre de 2016 a causa de una infección incurable provocada por una cepa de Klebsiella pneumoniae que era resistente a 26 antibióticos diferentes. Es decir, todos los disponibles en los Estados Unidos. Ninguno fue efectivo.

Mil millones de dólares para romper la resistencia
El problema ha alcanzado tal magnitud que, hace unos meses, más de 20 compañías biofarmacéuticas, con el apoyo de la Federación Internacional de Asociaciones y Fabricantes de Productos Farmacéuticos (IFPMA), anunciaron el lanzamiento del Fondo de Acción Resistencia a los Antimicrobianos (AMR). Este espera invertir más de 1000 millones de dólares en el desarrollo de tratamientos antibacterianos innovadores. El objetivo es desarrollar en 2030 de 2 a 4 nuevos antibióticos para los pacientes que sufren infecciones multirresistentes.Actualmente solo hay 32 tratamientos antibacterianos, en desarrollo clínico, dirigidos a la lista de patógenos prioritarios de la OMS. De estos, solo 6 cumplen al menos uno de los criterios de innovación definidos por la OMS. Nos estamos quedando rezagados y podemos perder la carrera. La innovación puede ser la clave. Según la última revisión de la OMS, de los 252 agentes antibacterianos que estaban en desarrollo preclínico, más de un tercio eran productos no tradicionales.
Si consideramos la gravedad del problema, urge un enfoque consensuado sobre nuevas estrategias. Por ello, es fundamental comunicar al público el peligro que representan estos patógenos y promover la concienciación en los hospitales y en los centros de investigación sobre la importancia de abordar el escenario sin esperar al futuro. También proporcionar un espacio abierto para la discusión de los diversos enfoques y nuevos hallazgos.
Mientras tanto, la población general debe arrimar el hombro. Debemos aplicar medidas de prevención y control.
- Tomar antibióticos solo cuándo los prescriba un profesional sanitario certificado. No comprarlos si no han sido recetados por un profesional.
- Seguir las instrucciones de los sanitarios respecto al uso de los antibióticos.
- Completar los tratamientos.
- No reutilizar antibióticos ni tomar los sobrantes de otro tratamiento.
- No usarlos para estimular el crecimiento de animales y administrarlos solo bajo supervisión veterinaria. Vacunar a los animales para reducir la necesidad de emplear estos fármacos.
- Prevenir las infecciones con las medidas higiénico-sanitarias pertinentes y manipular de forma correcta e higiénica los alimentos.
La OMS lo advierte y el refranero avisa: “Más vale prevenir que curar”.
Raúl Rivas González, Catedrático de Microbiología, Universidad de Salamanca
Este artículo fue publicado originalmente en The Conversation. Lea el original.

